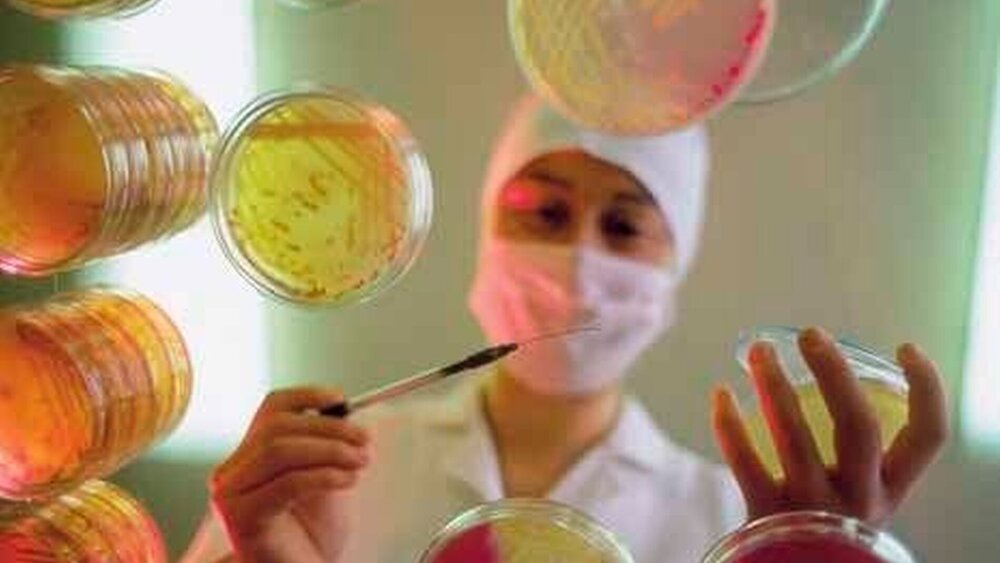

Bittere Pillen
KBV-Chef Dr. Andreas Köhler nahm kein Blatt vor den Mund: In mindestens zwei Fällen hätten Gutachter auf Druck der Arzneimittelhersteller darauf verzichtet, Expertisen für das Institut für Qualität und Wirtschaftlichkeit im Gesundheitswesen (IQWiG) zu schreiben. Grund: Die Pharma-Firmen hätten ansonsten die Gelder für die Forschung, „Drittmittel“ genannt, gestrichen. Indirekt stellte Köhler damit auch in Frage, ob das IQWiG seinen Auftrag überhaupt angemessen erfüllen kann.
„Die Androhung ist erfolgt“, sagte Köhler, der auch im Vorstand des IQWiG ist. Es gebe Gutachter, die sich inzwischen nicht mehr trauen, etwas vorzulegen, weil sie den Druck der Pharma-Industrie fürchten. Daraufhin hätten die Forscher auf eine Mitarbeit verzichtet.
Vorwürfe gegen die Pharmabranche
Cornelia Yzer, Hauptgeschäftsführerin des Verbandes Forschender Arzneimittelhersteller (VFA), beeilte sich, die Vorwürfe umgehend zurückzuweisen: Ihr Verband habe „von solchen Vorgängen keine Kenntnis.“ Es sollte „jetzt auch nicht versucht werden, das aufgrund seiner Auftragsvergabe in Verruf geratene IQWiG durch anonyme Vorwürfe gegen die Industrie zu entlasten.“
Keine Frage: Die Situation zwischen Institut und Industrie ist angespannt. Und die Position des IQWiG prekär. Soll das IQWiG doch, wie sein Name besagt, den Nutzen und die Wirtschaftlichkeit von Arzneimitteln beurteilen, also deren Wert oder Fragwürdigkeit abschätzen und entscheiden, welche von den Krankenkassen bezahlt werden und welche nicht. Aber weil eben davon die Erstattung der Medikamente abhängt, beeinflusst die Arbeit des Instituts direkt auch die Geschäfte der Industrie. Das 2004 von Bundesgesundheitsministerin Ulla Schmidt gegründete IQWiG fertigt die Studien jedoch nicht allein, die der Gemeinsame Bundesausschuss (G-BA) der Kassen und Ärzte ausschreibt. Die Aufträge gehen auch an externe Wissenschaftler. Und je mehr deren Arbeit durch die Industrie finanziert wird, desto eher kommt es zu Interessenkonflikten.
Insgesamt 80 Prozent der Medizinforschung werden durch Drittmittel finanziert, sagte Köhler. Damit schrumpfe die Zahl ausreichend qualifizierter und vor allem „neutraler“ Wissenschaftler. Köhler: „Das Problem ist nicht die Forschung, sondern die damit verbundene Beeinflussung des Forschers.“ Unterm Strich blieben sechs bis acht Einrichtungen, die man mit neutralen Expertisen beauftragen könne. Pharmakritische Wissenschaftler äußerten sich ähnlich. IQWiG-Chef Peter Sawicki hatte zuletzt verlangt, für die Anwendungsforschung müsse mehr Geld in die Hand genommen werden. „Mehr“ heißt ein Prozent der Kassenausgaben oder 1,5 Milliarden Euro im Jahr. Die Kassen lehnen das bisher ab.
Hoppe warnt
Ärztepräsident Prof. Dr. Jörg-Dietrich Hoppe will, dass mehr Steuergelder in die Forschung fließen. Er warnte freilich davor, „die Pharmaindustrie zu verteufeln“.
KBV-Chef Köhler will das Problem nun zusammen mit dem Gesundheitsministerium, den Wissenschaftlern und medizinischen Fachgesellschaften besprechen. Auch müsse das BMG beim Aufbau von mehr anwendungsorientierter Forschung helfen. Zu überlegen sei zudem, ob man bei IQWiGAufträgen nicht künftig auch englischsprachige Gutachten zulasse, denn international habe man weit mehr Auswahl an unabhängigen Forschungseinrichtungen. Köhler brachte auch ein Finanzierungsmodell ins Gespräch: Im Ausland zahlten Pharmahersteller Forschungsgelder in einen gemeinsamen Topf, aus dem dann die neutrale Nutzenforschung finanziert werde. Bei der Pharmaindustrie stößt das auf wenig Gegenliebe.Die forschenden Unternehmen hätten ihre Drittmittelvergabe „sauber“ geregelt, sagte Yzer: „Hier besteht – zumindest für uns – kein weiterer Handlungsbedarf.“